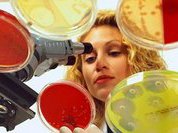
Туберкулёз и лекарственная устойчивость: поиск решений через партнёрство

От одного гена зависит, сколько мы проживем…
 Здоровье
Здоровье
 Здоровье
Здоровье
Американские ученые обнаружили, что отключение одного из генов иммунной системы под названием FAT10, способно продлевать жизнь. О данном гене известно, что он активизируется во время воспалений и связан с раком желудочно-кишечного тракта и половых органов.
Туберкулёз и лекарственная устойчивость: поиск решений через партнёрство
 Здоровье
Здоровье
Здоровье
Здоровье
24 марта, во Всемирный день борьбы с туберкулёзом, в Центральном Доме журналиста состоялся круглый стол "Туберкулёз и лекарственная устойчивость: поиск решений через партнёрство". В рамках мероприятия российские и международные эксперты обсудили инициативы по борьбе с болезнью.
- Мидии: едим круглый год. И в пост - тоже
- "Непрошенные гости": как их изничтожить?
- Стресс вызывает плохой запах изо рта
- Ананас поможет… усталым ногам
- Туберкулез по-прежнему "силен и стабилен"
- Ночная "серенада": почему возникает храп?
- В Томске разработают вакцины нового поколения от клещевого энцефалита
- В Удмуртии стартовала программа "Защити свой слух"
- Ранняя диагностика глаукомы сохранит зрение
- Обычная жвачка может вызвать мигрень
Нарушения сердечного ритма по-прежнему главная проблема кардиологии
 Здоровье
Здоровье
 Здоровье
Здоровье
На различные виды аритмии приходится примерно 10-15 % от всех сердечных заболеваний и летальных исходов
Анализ крови расскажет о продолжительности жизни
 Здоровье
Здоровье
 Здоровье
Здоровье
Ученые из финского Института молекулярной медицины заявляют, что по анализу крови можно предсказать, сколько человек проживет.
Одиночество - друг или враг?
 Психотерапия
Психотерапия
 Психотерапия
Психотерапия
Для чего нам нужно одиночество? Почему одни люди стремятся к нему всеми силами, но не могут получить, а другие не менее сильно его боятся, но никак не могут от него избавиться? Можно ли подружиться с одиночеством и "приручить" его, и нужно ли это делать вообще? А может, все просто: для кого-то одиночество необходимо, а кого-то – приводит к болезни?
Почти 60 человек погибли в Гвинее от лихорадки Эбола
 Здоровье
Здоровье
 Здоровье
Здоровье
В Гвинейской Республике зафиксирована вспышка лихорадки Эбола, в результате которой скончались уже 59 человек.
- Бактерии прибавят нам ума?
- "Скорбная болезнь" уже излечима?
- "Тройственный союз" вступает в борьбу за красоту
- Желудок - главный барометр погоды
- В чем волшебство магнита?
- Украина объявила войну кодеиновой наркомании
- Седина - признак хорошего здоровья
- Первое в мире пересаженное искусственное сердце остановилось из-за замыкания
- "Подушка безопасности" для пациента
- Негативные эмоции накапливаются в печени

